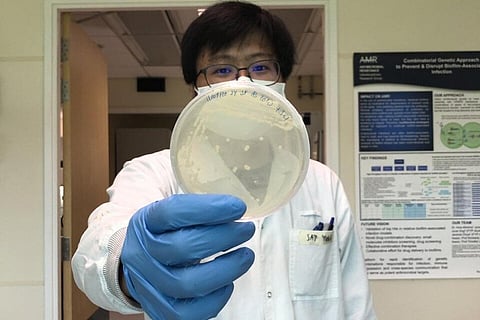

वैज्ञानिकों ने एक नया तरीका खोजा है जिसमें हाइड्रोजन सल्फाइड की मदद से कुछ बैक्टीरिया जो एंटीबायोटिक रेसिस्टेंट हो चुके हैं, उन्हें फिर एंटीबायोटिक के प्रति संवेदनशील बनाया जा सकता है| यह शोध सिंगापुर-एमआईटी एलायंस फॉर रिसर्च एंड टेक्नोलॉजी (स्मार्ट) के शोधकर्ताओं द्वारा किया गया है, जोकि जर्नल फ्रंटियर्स इन माइक्रोबायोलॉजी में प्रकाशित हुआ है|
शोध के अनुसार अब तक जिन बैक्टीरिया पर शोध किया गया है, उनमें एंटीबायोटिक से बचने के लिए स्वाभाविक रूप से हाइड्रोजन सल्फाइड बनता है| जो एंटीबायोटिक दवाओं से बचने के लिए बैक्टीरिया में एक सुरक्षा तंत्र को बनाता है|
इसे समझने के लिए स्मार्ट के शोधकर्ताओं ने एसिनोटोबैक्टर बॉमनेई नामक रोगजनक बैक्टीरिया में हाइड्रोजन सल्फाइड को मिलाने का प्रयास किया| इस बैक्टीरिया की ख़ास बात यह है कि यह स्वयं हाइड्रोजन सल्फाइड को नहीं बनाता| वैज्ञानिकों को पता चला कि जब इस बैक्टीरिया में अलग से हाइड्रोजन सल्फाइड मिलाया गया तो उसने इसमें एंटीबायोटिक से बचने का गुण पैदा करने की जगह उसे एंटीबायोटिक के प्रति और संवेदनशील बना दिया| टैस्ट में यह बैक्टीरिया जेंटामाइसिन नामक एंटीबायोटिक के प्रति भी संवेदनशील बन गया था| गौरतलब है कि जेंटामाइसिन एक बहुत ही आम एंटीबायोटिक है जो कई प्रकार के संक्रमणों का इलाज करता है|
इस शोध से जुड़े शोधकर्ता विल्फ्रेड मोरेरा ने बताया कि अब तक यही जाना जाता था कि हाइड्रोजन सल्फाइड बैक्टीरिया को एंटीबायोटिक दवाओं से बचाता है जिससे वो एंटीबायोटिक रेसिस्टेंट बन जाते हैं| पर इस शोध से पता चला है कि जो बैक्टीरिया स्वाभाविक रूप से हाइड्रोजन सल्फाइड को नहीं बनाते उनमें यह एंटीबायोटिक रेसिस्टेंट बैक्टीरिया को फिर से एंटीबायोटिक दवाओं के प्रति संवेदनशील बना सकता है|
वैज्ञानिकों का अनुमान है कि दुनिया में एंटीबायोटिक रेसिस्टेंट एक बड़ा खतरा है| अनुमान है कि यदि इस पर ध्यान नहीं दिया गया तो 2050 तक इसके कारण हर साल करीब 1 करोड़ लोगों को अपनी जान गंवानी पड़ सकती है| वहीं विश्व स्वास्थ्य संगठन के अनुसार 2030 तक इसके कारण 2.4 करोड़ लोग अत्यधिक गरीबी का सामना करने को मजबूर हो जाएंगे| साथ ही इससे वैश्विक अर्थव्यवस्था को भी भारी नुकसान उठाना पड़ेगा| ऐसे में सही समय पर इनसे निपटना जरुरी है|
हालांकि यह शोध एसिनोटोबैक्टर बॉमनेई नामक बैक्टीरिया पर किया गया है पर शोधकर्ताओं का मानना है कि यह उन अन्य बैक्टीरिया पर भी इसी तरह काम करेगा जो स्वाभाविक रूप से हाइड्रोजन सल्फाइड नहीं बनाते| यदि ऐसा होता है तो यह न केवल एसिनोटोबैक्टर बॉमनेई बल्कि उस जैसे अनेकों बैक्टीरिया और उनसे फैलने वाले रोगों को रोकने के लिए वरदान साबित हो सकता है|